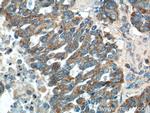
tPA Antibody in Immunohistochemistry (Paraffin) (IHC (P))

Search
Proteintech
tPA Polyclonal Antibody
{{$productOrderCtrl.translations['antibody.pdp.commerceCard.promotion.promotions']}}
{{$productOrderCtrl.translations['antibody.pdp.commerceCard.promotion.viewpromo']}}
{{$productOrderCtrl.translations['antibody.pdp.commerceCard.promotion.promocode']}}: {{promo.promoCode}} {{promo.promoTitle}} {{promo.promoDescription}}. {{$productOrderCtrl.translations['antibody.pdp.commerceCard.promotion.learnmore']}}
产品信息
10147-1-AP
种属反应
已发表种属
宿主/亚型
分类
类型
抗原
偶联物
形式
浓度
规格
纯化类型
保存液
内含物
保存条件
运输条件
产品详细信息
Immunogen sequence: TYDNDIALL QLKSDSSRCA QESSVVRTVC LPPADLQLPD WTECELSGYG KHEALSPFYS ERLKEAHVRL YPSSRCTSQH LLNRTVTDNM LCAGDTRSGG PQANLHDACQ GDSGGPLVCL NDGRMTLVGI ISWGLGCGQK DVPGVYTKVT NYLDWIRDNM RP (356-516 aa encoded by BC002795)
靶标信息
TPA converts the abundant, but inactive, zymogen plasminogen to plasmin by hydrolyzing a single Arg-Val bond in plasminogen. By controlling plasmin-mediated proteolysis, it plays an important role in tissue remodeling and degradation, in cell migration and many other physio pathological events. It specifically cleaves the Arg- -Val bond in plasminogen to form plasmin, and is comprised of a heterodimer of chain A and chain B held by a disulfide bond. TPA binds to fibrin with high affinity. This interaction leads to an increase in the catalytic efficiency of the enzyme between 100-and 1000-fold, due to an increase in affinity for plasminogen. Similarly, binding to heparin increases the activation of plasminogen. Binding to laminin and fibronectin has also been demonstrated. TPA also binds to mannose receptor and the low-density lipoprotein receptor-related protein (LRP1). These proteins are involved in TPA clearance. TPA binds to annexin II and to cytokeratin 8. As yet unidentified interactions on endothelial cells and vascular smooth muscle cells (VSMC) lead to a 100-fold stimulation of plasminogen activation. In addition, binding to VSMC reduces TPA inhibition by PAI-1 by 30-fold.
仅用于科研。不用于诊断过程。未经明确授权不得转售。
生物信息学
蛋白别名: 3.4.21.68; alteplase; plasminogen activator; plasminogen/activator kringle; reteplase; t plasminogen activator; t-PA; t-plasminogen activator; tissue plasminogen activator; Tissue-type plasminogen activator; unnamed protein product
基因别名: AU020998; AW212668; D8Ertd2e; PATISS; PLAT; T-PA; TPA
UniProt ID: (Human) P00750, (Mouse) P11214, (Rat) P19637
Entrez Gene ID: (Human) 5327, (Mouse) 18791, (Rat) 25692